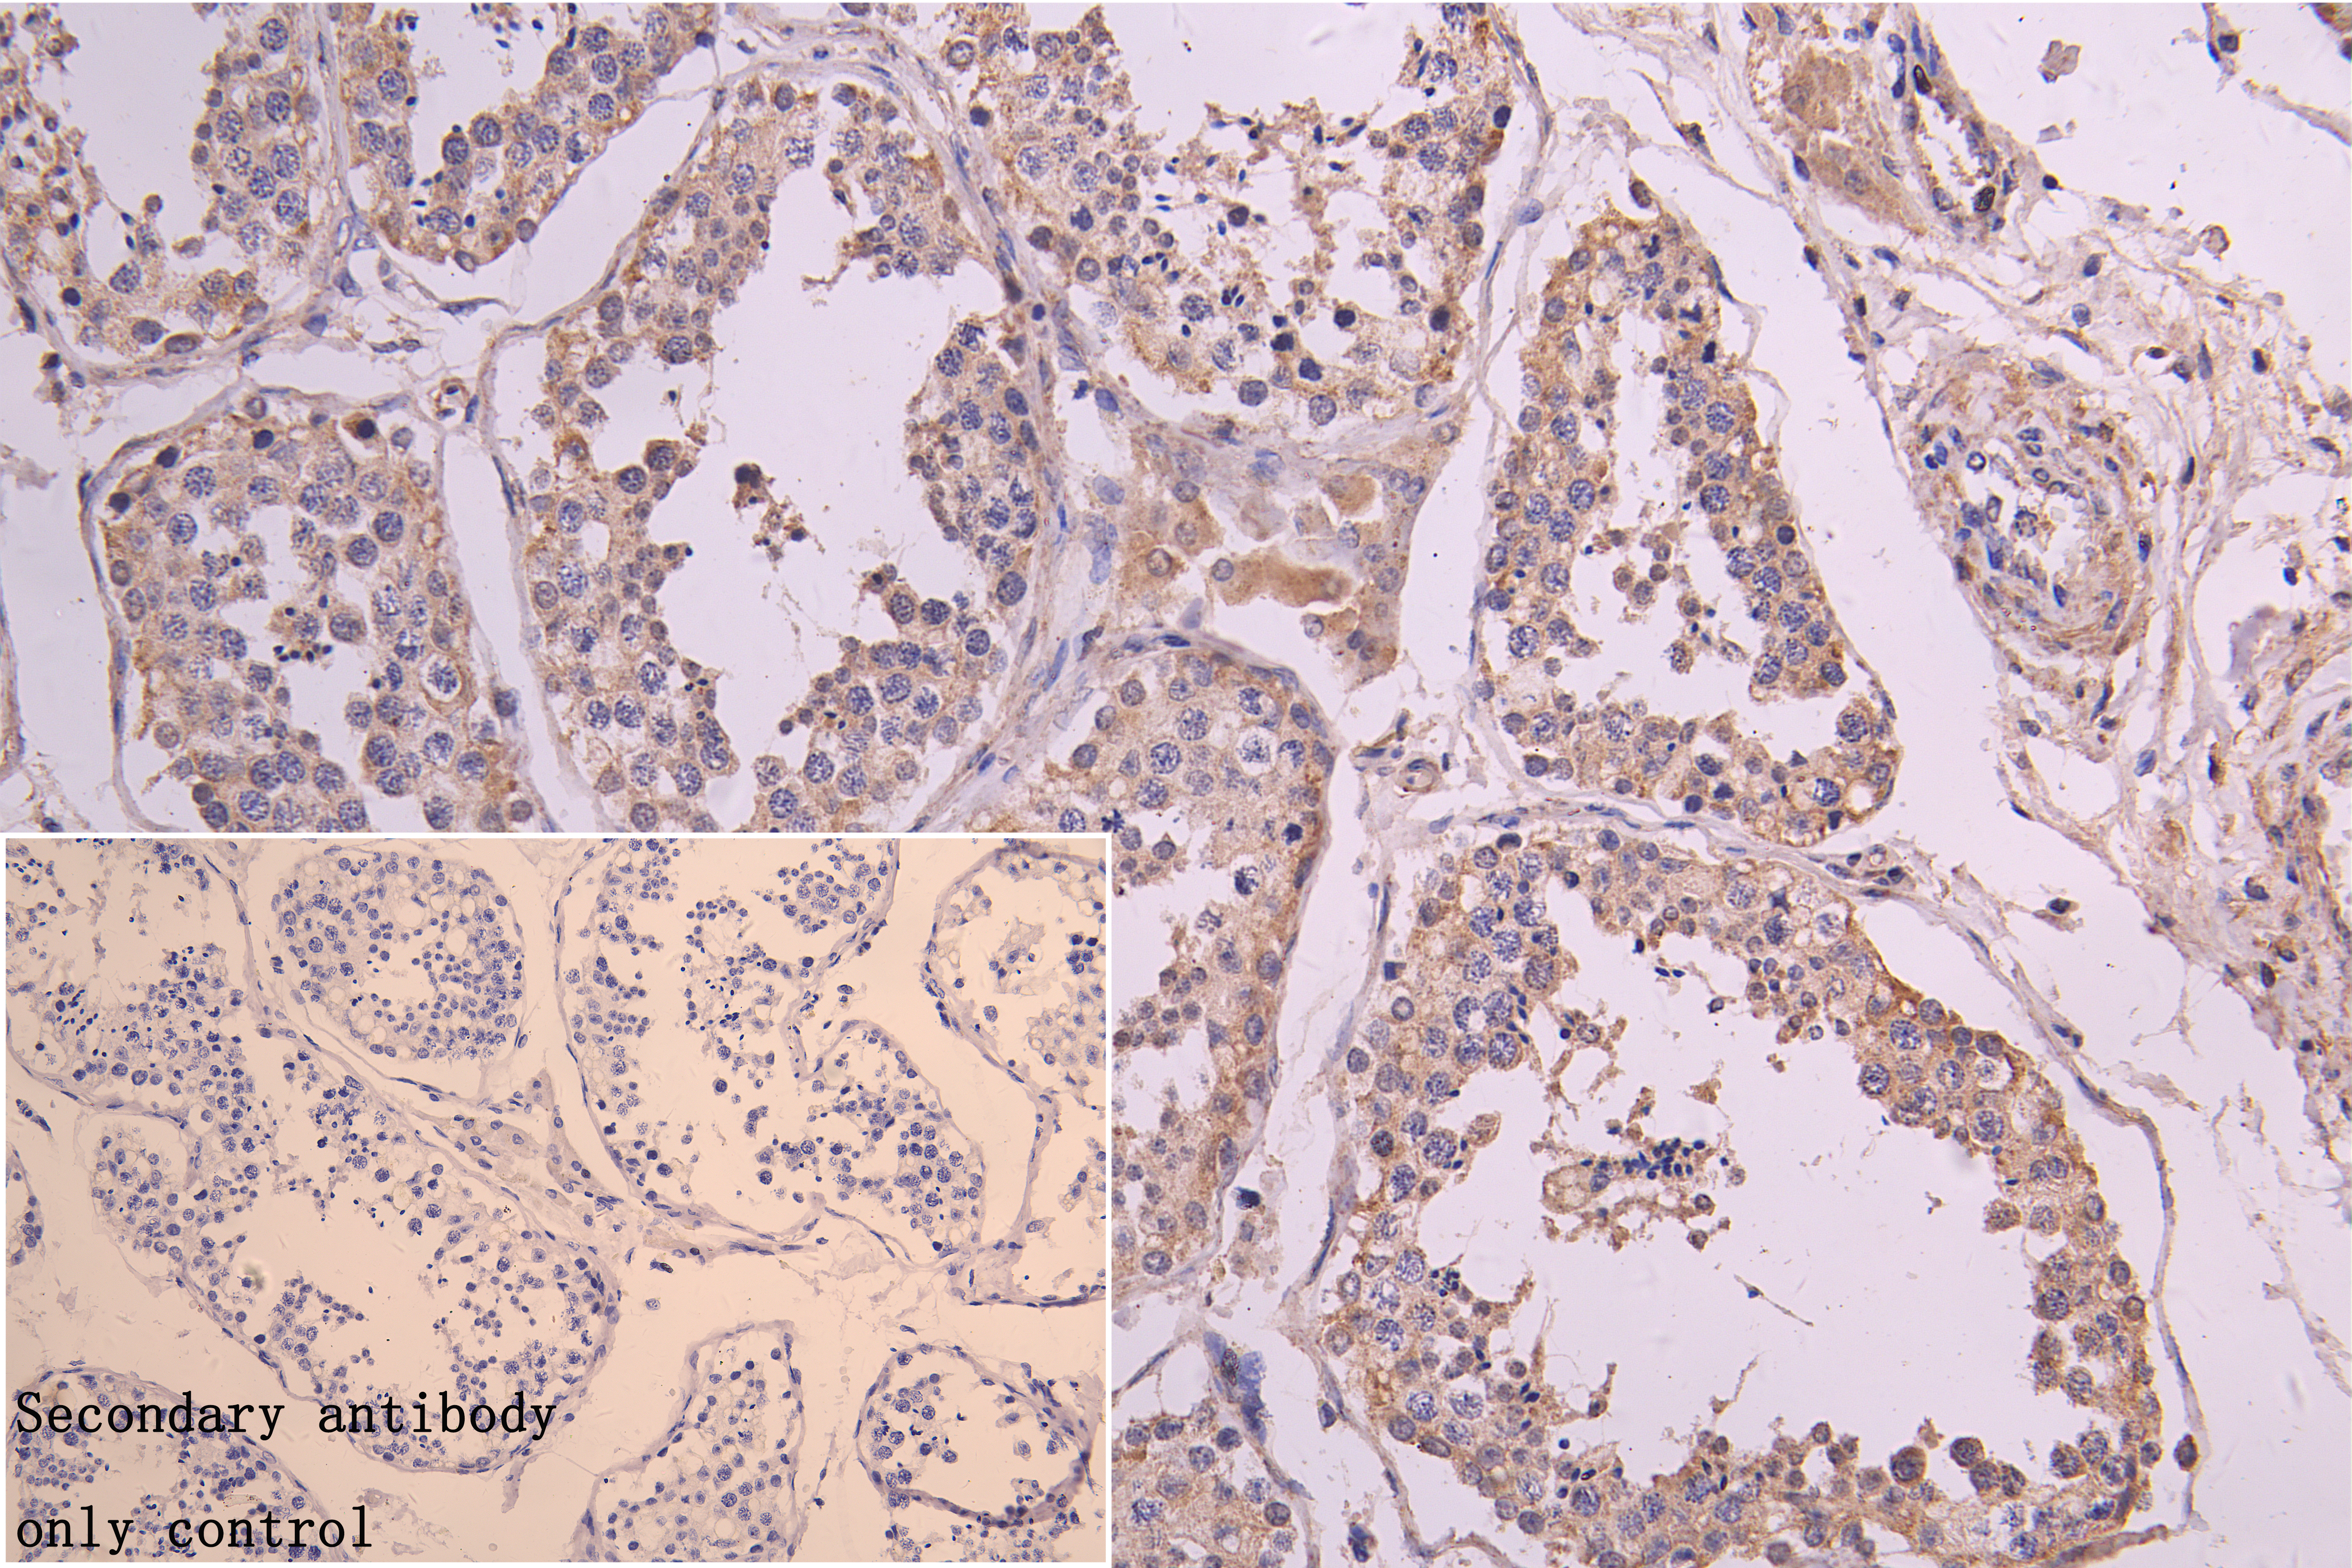

RNF126 Antibody
-
中文名稱:RNF126兔多克隆抗體
-
貨號:CSB-PA019828LA01HU
-
規(guī)格:¥440
-
圖片:
-
Western Blot
Positive WB detected in: Mouse Liver tissue lysate
All lanes: RNF126 antibody at 1:5000
Secondary
Goat polyclonal to rabbit IgG at 1/50000 dilution
Predicted band size: 36 kDa
Observed band size: 36 kDa -
IHC image of CSB-PA019828LA01HU diluted at 1:300 and staining in paraffin-embedded Human testis tissue performed on a Leica BondTM system. After dewaxing and hydration, antigen retrieval was mediated by high pressure in a citrate buffer (pH 6.0). Section was blocked with 10% normal goat serum 30min at RT. Then primary antibody (1% BSA) was incubated at 4°C overnight. The primary is detected by a Goat anti-rabbit polymer IgG labeled by HRP and visualized using 0.05% DAB.
-
IHC image of CSB-PA019828LA01HU diluted at 1:300 and staining in paraffin-embedded human pancreatic tissue performed on a Leica BondTM system. After dewaxing and hydration, antigen retrieval was mediated by high pressure in a citrate buffer (pH 6.0). Section was blocked with 10% normal goat serum 30min at RT. Then primary antibody (1% BSA) was incubated at 4°C overnight. The primary is detected by a Goat anti-rabbit polymer IgG labeled by HRP and visualized using 0.05% DAB.
-
IHC image of CSB-PA019828LA01HU diluted at 1:300 and staining in paraffin-embedded human liver cancer performed on a Leica BondTM system. After dewaxing and hydration, antigen retrieval was mediated by high pressure in a citrate buffer (pH 6.0). Section was blocked with 10% normal goat serum 30min at RT. Then primary antibody (1% BSA) was incubated at 4°C overnight. The primary is detected by a Goat anti-rabbit polymer IgG labeled by HRP and visualized using 0.05% DAB.
-
Immunofluorescence staining of Hela cell with CSB-PA019828LA01HU at 1:30, counter-stained with DAPI. The cells were fixed in 4% formaldehyde and blocked in 10% normal Goat Serum. The cells were then incubated with the antibody overnight at 4C. The secondary antibody was Alexa Fluor 488-congugated AffiniPure Goat Anti-Rabbit IgG(H+L).
-
Immunofluorescence staining of Hela cell with 5% goat serum, counter-stained with DAPI. The cells were fixed in 4% formaldehyde and blocked in 10% normal Goat Serum. The cells were then incubated with the antibody overnight at 4C. The secondary antibody was Alexa Fluor 488-congugated AffiniPure Goat Anti-Rabbit IgG(H+L).
-
-
其他:
產(chǎn)品詳情
-
產(chǎn)品描述:
The rabbit anti-human RNF126 polyclonal antibody is an IgG generated by immunizing rabbits with the recombinant human E3 ubiquitin-protein ligase RNF126 protein (39-225aa). RNF126 regulates protein turnover and stability by promoting the ubiquitination and degradation of its target proteins, which is critical for maintaining cellular homeostasis and regulating various cellular processes. RNF126 has been implicated in several cellular processes, including the regulation of immune response, DNA repair, and cell cycle progression.
This RNF126 polyclonal antibody underwent protein G affinity chromatography purification, getting a purity of up to 95%. This RNF126 antibody is designed to specifically bind to human and mouse RNF126 proteins and is recommended for use in ELISA, WB, IHC, and IF applications to detect and measure the levels of RNF126 protein.
-
產(chǎn)品名稱:Rabbit anti-Homo sapiens (Human) RNF126 Polyclonal antibody
-
Uniprot No.:
-
基因名:RNF126
-
別名:E3 ubiquitin-protein ligase RNF126 antibody; FLJ20552 antibody; MGC1022 antibody; MGC14317 antibody; RING finger protein 126 antibody; RN126_HUMAN antibody; RNF 126 antibody; RNF126 antibody
-
宿主:Rabbit
-
反應種屬:Human, Mouse
-
免疫原:Recombinant Human E3 ubiquitin-protein ligase RNF126 protein (39-225AA)
-
免疫原種屬:Homo sapiens (Human)
-
標記方式:Non-conjugated
本頁面中的產(chǎn)品,RNF126 Antibody (CSB-PA019828LA01HU),的標記方式是Non-conjugated。對于RNF126 Antibody,我們還提供其他標記。見下表:
-
克隆類型:Polyclonal
-
抗體亞型:IgG
-
純化方式:>95%, Protein G purified
-
濃度:It differs from different batches. Please contact us to confirm it.
-
保存緩沖液:Preservative: 0.03% Proclin 300
Constituents: 50% Glycerol, 0.01M PBS, pH 7.4 -
產(chǎn)品提供形式:Liquid
-
應用范圍:ELISA, WB, IHC, IF
-
推薦稀釋比:
Application Recommended Dilution WB 1:500-1:5000 IHC 1:200-1:500 IF 1:20-1:100 -
Protocols:
-
儲存條件:Upon receipt, store at -20°C or -80°C. Avoid repeated freeze.
-
貨期:Basically, we can dispatch the products out in 1-3 working days after receiving your orders. Delivery time maybe differs from different purchasing way or location, please kindly consult your local distributors for specific delivery time.
-
用途:For Research Use Only. Not for use in diagnostic or therapeutic procedures.
相關產(chǎn)品
靶點詳情
-
功能:E3 ubiquitin-protein ligase that mediates ubiquitination oF target proteins. Depending on the associated E2 ligase, mediates 'Lys-48'- and 'Lys-63'-linked polyubiquitination of substrates. Part of a BAG6-dependent quality control process ensuring that proteins of the secretory pathway that are mislocalized to the cytosol are degraded by the proteasome. Probably acts by providing the ubiquitin ligase activity associated with the BAG6 complex and be responsible for ubiquitination of the hydrophobic mislocalized proteins and their targeting to the proteasome. May also play a role in the endosomal recycling of IGF2R, the cation-independent mannose-6-phosphate receptor. May play a role in the endosomal sorting and degradation of several membrane receptors including EGFR, FLT3, MET and CXCR4, by mediating their ubiquitination. By ubiquitinating CDKN1A/p21 and targeting it for degradation, may also promote cell proliferation. May monoubiquitinate AICDA.
-
基因功能參考文獻:
- Studies present the solution structure of the RNF126_NZF (N-terminal zinc finger domain) as well as the structure of RNF126_NZF/BAG6_UBL complex and characterize the interaction of RNF126 with the UBL domains from both BAG6 and UBL4A from the BAG6 sortase complex. PMID: 27193484
- RNF126 depletion results in frataxin accumulation in cells derived from FRDA patients. PMID: 28228265
- These data suggested that RNF126 might be related to the progression of tongue cancer through regulating AKT signaling pathway. PMID: 27227488
- RNF126 is a novel regulator of NHEJ that promotes completion of DNA repair by ubiquitylating Ku80 and releasing Ku70/80 from damaged DNA. PMID: 27895153
- this results suggest a novel role of RNF126 in promoting Homologous recombination-mediated repair through positive regulation on BRCA1 expression by direct interaction with E2F1. PMID: 26234677
- RNF126 is recruited to the N-terminal Ubl domain of Bag6 and preferentially ubiquitinates juxtahydrophobic lysine residues on Bag6-associated clients. PMID: 24981174
- The ubiquitin ligase RNF126 has a role in the retrograde sorting of the CI-MPR. PMID: 24275455
- RNF126 and Rabring7 play a role in the ubiquitin-dependent sorting and downregulation of membrane receptors. PMID: 23418353
- identify a unique cofactor, RING finger protein 126 (RNF126), verify its interaction by traditional techniques, and show that it has functional consequences as RNF126 is able to ubiquitylate activation-induced cytidine deaminase PMID: 23277564
- These findings suggest that RNF126 promotes cancer cell proliferation by targeting p21 for ubiquitin-mediated degradation PMID: 23026136
顯示更多
收起更多
-
亞細胞定位:Cytoplasm. Nucleus.
-
組織特異性:Highly expressed in liver and testis.
-
數(shù)據(jù)庫鏈接:
Most popular with customers
-
-
YWHAB Recombinant Monoclonal Antibody
Applications: ELISA, WB, IHC, IF, FC
Species Reactivity: Human, Mouse, Rat
-
Phospho-YAP1 (S127) Recombinant Monoclonal Antibody
Applications: ELISA, WB, IHC
Species Reactivity: Human
-
-
-
-
-